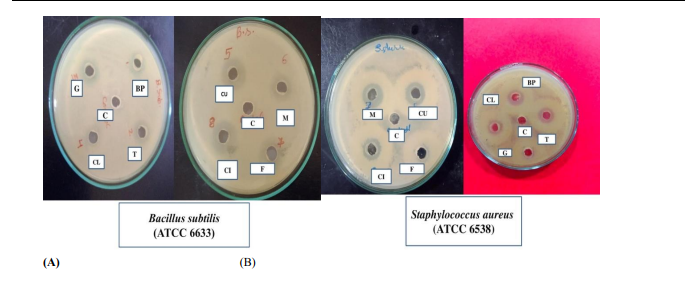
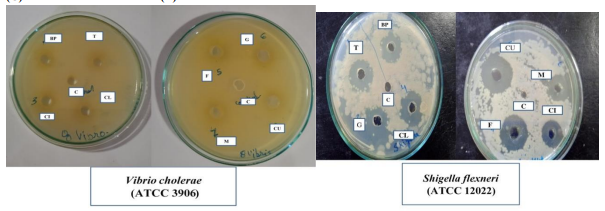

AUCTORES
Globalize your Research
Research Article | DOI: https://doi.org/10.31579/2690-8816/124
1Swami Vivekanand Subharti University, NH-58, Subhartipuram, Meerut-250005 India
2School of Biological Engineering & Life Sciences, Shobhit Institute of Engineering & Technology, (NAAC accredited grade "A", Deemed to- be-University), Meerut -250110, India
*Corresponding Author: Amar P Garg. Swami Vivekanand Subharti University, NH-58, Subhartipuram, Meerut-250005 India
Citation: Amar P Garg. (2024). Antimicrobial Activities of Aqueous Extracts of Selected Indian Spices Against Food Borne and Enteropathogens, J. Clinical Research Notes, 5(2) DOI: 10.31579/2690-8816/124.
Copyright: © 2024 Amar P Garg. This is an open-access article distributed under the terms of The Creative Commons Attribution License, which permits unrestricted use, distribution, and reproduction in any medium, provided the original author and source are credited.
Received: 23 February 2024 | Accepted: 04 March 2024 | Published: 12 March 2024
Keywords: phytochemicals; phenolics; tannins; flavonoids; alkaloids; phenolic; antimicrobial activities.
Spices have been used by the people for generations as flavorings, digestive, coloring, taste enhancer, preservatives, and as medications due to their various properties. Ayurveda says that they help to maintain body fluid balance. Post covid-19, the consumers are demanding foods with bio-preservatives; hence, this study aimed to evaluate antimicrobial abilities of various spices against common food borne pathogens to increase shelf life of the spices added food products without addition of harmful chemical preservatives. The confidence of people in the use of plant parts as natural medicines to prevent and cure diseases, has increased as they are considered safe and are as effective as allopathic medication without any side effects. Spices are plant parts like seeds, barks, stems, flowers, roots, leaves, etc. Each spice has characteristic aroma and is mainly used during cooking to impart flavor, color,to enhance taste of the dish, in spiritual rituals and also possess medicinal values. Various phytochemicals compounds like phenolics, tannins, flavonoids, saponins, and alkaloid etc are present in spices. The use of spices has been associated with several health benefits, including digestion and high nutritional value. Aqueous extract of various spices -turmeric (Curcuma longa), black pepper (Piper nigrum), fenugreek (Trigonella foenum-graecum), garlic (Allium sativum), mustard (Brassica repa subsp. oleifera), clove (Syzygium aromaticum), cumin (Cuminum cyminum) and cinnamon (Cinnamomum verum) were studied against common food borne and Enteropathogens i.e Pseudomonas aeruginosa (ATCC 9027), Bacillus subtilis (ATCC 6633), Shigella flexneri (ATCC 12022), Cronobacter sakazakii (ATCC 29544), Escherichia coli (ATCC 8739), Staphylococcus aureus (ATCC 6539), Salmonella enterica (ATCC 14028), and Vibrio cholerae (ATCC 3906) using agar well diffusion method. Black pepper was found highly active against Staphylococcus aureus, Bacillus subtilis, Salmonella enterica, and Escherichia coli whereas cinnamon was active against Cronobacter sakazakii and Pseudomonas aeruginosa. Aqueous extracts of clove exhibited antibacterial activity against Shigella flexneri, Salmonella enterica and E. coli. Cumin was moderately active against E. coli, Cronobacter sakazakii, Salmonella enterica and Shigella flexneri. Garlic exhibited high activity against Salmonella flexneri, E. coli and Bacillus subtilis, while turmeric was active against Bacillus subtilis, Salmonella enterica and Staphylococcus aureus only. Vibrio cholerae showed moderate sensitivity to all test spices turmeric, clove, garlic, cumin, cinnamon, black pepper, mustard and fenugreek. It is suggested that a combination of spices in Indian kitchen as additive in food products is advantageous over single use of an spice. We had planned and conducted all experiments with aqueous extracts with a view that only watersoluble phytochemicals are readily available to the microbes in the food products when they are added as flavoring, coloring or aromatic agents.
Since the day break of time, spices have been significant to humans. The "Epic of Gilgamesh" and the "Bhagavad Gita," among other incredible literature, have mentioned their use for a variety of purposes. Several traditional kitchen formulations in India are frequently referred to as Ayurvedic nourishments having similarities withAyurvedic dietetics and traditional cuisines [1]. Spices have been used by human for thousands of years, not only in India but were exported to various countries like Egypt, Iran, Africa and other ancient nations [2]. The ability of spices to conserve natural moisture of the foods made them excellent for preserving. They contribute to the preservation of the body's temperature, in understanding with Ayurveda [3]. Spices were used as flavoring agent, to impart color in food as well these were used as a treatment of various infections like cough, sneezing etc [4, 5]. The spices contained different types of bio-molecules commonly referred as phytocompounds such as flavonoids, tannins, alkaloids, etc. that perform certain organic capacities that fortify restorative exercises such as anti-cancer, anti-mutagenic properties, anti-inflammatory, and antioxidant and anti-microbial activities [6-10]. Spices are utilized within the pharmaceutical, naturopathic, nourishment additive, corrective, food andbio-pesticide industries, whereas they play a significant role in financial management and quality of products of the companies [11]. The garlic,a monocotyledonous herb Allium sativum, is the second most extensively distributed species of Allium in the globe [12], belongs to the family Alliaceae. Garlic is used to flavour the food and has several medicinal advantages [13]. It is crucial to maintain garlic as a staple export crop for a very long time [14]. Garlic is a good source of folic acid, vitamin C, calcium, iron, magnesium, potassium, zinc, and vitamins B2, B1, and B3, highly rich in nutrients, minerals and help in dehydration [15]. Flavonoids, phenolics, and other phytochemical components extracted from spices have the natural capacity to protect the foods by restraining microbial growth, oxidation, and specific chemical reactions in nourishment items [16]. Spices contain phytochemicals that are beneficial in the pharmaceutical, food, and meat industries, that are putting high emphasis on spice-based additives. Cloves, garlic, ginger, cinnamon, thyme, oregano, and basil are mostly used as seasonings [1, 7]. Food-borne infections may be caused by antimicrobial resistance in some bacteria. Many spices are used to extend the shelf life of food and to anticipate food-borne illnesses. While certain spices are essential in the food industry, many are also useful for repressing irreversible infections and inhibit pathogens, particularly in traditional healthcare [17]. Manufactured chemical additives are added to various food products that are now rejected by health conscious clients. Spices and herbs are safe alternatives to chemical additives used in food products [6].
Spices are largely used in the food market, but they are also used in the pharmaceutical, beauty care products, perfume, and pharmaceutical industries [18]. Mustard (Brassica spp.) is a key group among the world's oil seed crops. It is the world's third most important source of edible oil. Mustard’s nutritional and functional qualities are attributed to their fatty acid composition and fatty acid distribution pattern within the triacylglycerol molecule [10, 19]. Clove oil is extracted from the flower buds of Syzygium aromaticum, a plant belonging to the family Myrtaceae, is a precious spice and has been used as for food preservation and medicine for millennia due to its antibacterial and antioxidant characteristics [6,11].
Since ancient times, people have used turmeric (Curcuma longa), which is now a major ingredient in many Asian dishes with numerous medicinal value. Turmeric, India's sacred spice is frequently used as a condiment, flavoring ingredient, culinary additive, and powerful additive [20]. It has been designated as a medicinal agent in the treatment of several illnesses in traditional Ayurvedic, Unani, and Siddha pharmaceutical systems [21]. Turmeric has traditionally been used as a home remedy in the treatment of various infections such as anorexia, attack, sickness, and digestive system clutter. Non-curcuminoids found in turmeric include calebin A, turmerone, elemen, bisacurone, cardion, bisabolone, caseren, furanodiene, ferulic corrosive, and coumaric corrosive, Demethoxycurcumin (about 18%), bisdemethoxycurcumin (about 5%), and curcumin constitute the majority of commercially available curcuminoids. Curcumin has been shown to be the most physiologically dynamic phytochemical of them all [22]. Turmeric contains polyphenolic component that is used to treat diabetes mellitus all over the world [23]. Turmeric has also been associated with pharmacological effects such as anti-inflammatory, antibacterial, anticancer, antioxidant with hypolipidemic effects. It is crucial to note that the majority of these effects are related to the proximity of bioactive phenolic acids [15]. An antioxidant potential of 45 genotypes in turmeric of was investigated, and it was discovered that both non-curcuminoids and curcuminoids contribute to turmeric's antioxidant effect [24]. Spices containing phenolic chemicals are well-known for their significant antioxidant and antibacterial properties [25]. Turmeric's physiologically active components, ar-turmerone, and -turmerone, have been shown to have antibacterial, antioxidant, anti-inflammatory, and anticancer properties [26]. Turmeric oil is also commonly utilized in pharmacological and therapeutic products. As a result, the foundation of turmeric's beneficial effects is made up of both curcuminoids and unstable fixes [27].
Black pepper (Piper nigrum) is an Indian spice, and its essential oil has been shown to have antimicrobial activity [28]. In Black pepper, phenolic components are considered to be responsible for its antibacterial activity, deteriorating bacterial films, and inhibiting bacterial growth [29]. Piperine, pyrrolein B, and piperamide have been discovered to be the most important critical constituents in black pepper. Based on acetone extraction, this essential oil has been shown to be effective in inhibiting mycelial growthof Fusarium graminearum and Penicillium viridcatum [11]. Black pepper has been shown to exhibit antibacterial activity with inhibitory doses ranging from 50 to 500 ppm. It appears to be a significant inhibitor of the growth of Gram-positive microscopic organisms such as Staphylococcus aureus, Bacillus cereus, and Streptococcus faecalis, as well as a few Gram-negative microscopic species such as Pseudomonas aeruginosa [29]. Fenugreek (Trigonella faenum-graecum) used as a spice and herb in various cuisines, and the only edible portions of the plant are green leaves and seeds. Leaves are used to flavor meals or eaten as greens in Indian cuisine, while seeds are used as seasonings or crushed to make curry powders and pastes. Fenugreek is used as a bread addition in African cuisine. The presence of galactomannan, a source of soluble dietary fiber in seed endosperm, increases the bread's nutritional and physicochemical qualities [30]. It is used as mouth freshner and possesses antimicrobial activity [31a]. Microbial contamination is a key source of food decomposition and deterioration. Spices are used to protect foods against bacteria, fungi such as mould and yeast [9]. The aim of this study was to determine the antimicrobial activities of selected Indian spices-turmeric (Curcuma longa), black pepper (Piper nigrum), fenugreek (Trigonella foenum-graecum), garlic (Allium sativum), mustard (Brassica repa), clove (Syzygium aromaticum), cumin (Cuminum cyminum) and cinnamon (Cinnamomum verum) on different common food borne and Enteropathogens bacteria that included Pseudomonas aeruginosa (ATCC 9027), Bacillus subtilis (ATCC 6633), Shigella flexneri (ATCC 12022), Cronobacter sakazakii (ATCC 29544), Escherichia coli (ATCC 8739), Staphylococcus aureus (ATCC 6539), Salmonella enterica (ATCC 14028), and Vibrio cholerae (ATCC 3906) using agar well diffusion method. Phytochemical components of their extracts were also analyzed in order to their antibacterial properties.
Collection Of Sample And Their Preparation
Fresh turmeric (Curcuma longa), black pepper (Piper nigrum), fenugreek (Trigonella foenum-graecum), garlic (Allium sativum), mustard (Brassica repa), clove (Syzygium aromaticum), cumin (Cuminum cyminum) and cinnamon (Cinnamomum verum) were purchased from the local market of Meerut, Uttar Pradesh. These were sorted out to remove visible impurities if any, gently washed using running tap water, wiped with a clean dry cloth, then sun-dried [32 a,b]. The spices were then crushed into powder using a mortar and pestle [33].
Extract Preparation
2 g (w/w) of powder of above spices was suspended in 20 mL of sterile distilled water overnight, and then centrifuged at 5000 rpm for 15 min at 4℃. The supernatant was collected and filtered through Whatman’s filter paper No. 1 [34].
Yield (gram) × 100
Yield% = -------------------------------
Initial weight (gram)
Proximate Analysis Of Spices.
For proximate analysis of spices, moisture content, solubility in water and ash content were determined using AOAC method (2005). Moisture content was calculated by subtracting the initial weight placed in oven from final weight of spices after drying in oven at 55°C [35]. The solubility was determined by total amount of water added in spices subtracted from total weight of spices after water evaporated while total ash was estimated by heating known amount of spice at temperature 550°C for 5 to 6 hours in muffle furnace [32(a, b), 36] using following formulae.
weight of ash × 100
Ash content% = -------------------------------
Weight of sample
Preliminary Phytochemicals Analysis Of Spices
AOAS methods described by Trease and Evans (1990) [see: 32 a, b] were used for phytochemicals screening of an aqueous extract of spices prepared.
(a) Mayer’s Test: 2 mL of the aqueous extract sample was mixed with 4-5 drops of Mayer's reagent composed of 1.36 g mercuric chloride and 5 g potassium iodide in 100mL of distilled water. The presence of alkaloids was demonstrated by the formation of a white precipitate [32 a b].
(b) Wagner’s Test: Wagner’s reagent (1.3 g of iodine and 3g of potassium iodide added into 100mL of distilled water) mixed with 2mL of water extract in the sterile test tube. The presence of alkaloid showed by reddish brown precipitation [33].
Detection Of Flavonoids
(b) Sulphuric acid test: 2 mL aqueous extract of sample was mixed with few drops of concentrated sulphuric acid (H2SO4). The formation of red or orange precipitation indicated the presence of flavonoids [37].
Detection Of Tannins
(a) Feeric Chloride test: 1 ml of aqueous extract of sample was transferred in a test tube, and 5
Moisture content is essential for proper flavor and aroma formation of the spices. Fig 1 shows that garlic (32.4%) possessed highest percentage of moisture content, followed by turmeric (28.6%), mustard (26.62%), cinnamon (20.45%), clove (18.5%) and cumin (10.96) whereas black pepper (9.2%) had the lowest moisture content when compared to turmeric, clove, cumin, cinnamon, mustard, and fenugreek (Fig. 1).
The percentage of solubility is significant because the constituent phytochemicals of the spices must be transmitted in water soluble form for a proper metabolic functions [40]. We found that garlic (42.4%) had the highest solubility in water followed by cumin, turmeric, cinnamon, clove, black pepper, fenugreek and mustard (6.3%) had the lowest aqueous solubility percentage (Fig. 1), possibly because of the presence of insoluble fatty acids as its constituent [41-45]. The ash content of spices may influence their physiochemical as well as nutritional properties [15]. The ash content of the spice showed that mustard, cumin, garlic and black pepper had high ash content, whereas cinnamon (2.4%) had a low ash content as compared to turmeric, clove, cumin, garlic, black pepper, whereas turmeric, fenugreek and clove yielded lesser ash content and cinnamon possessed the lowest (Fig. 1). High percent of ash content suggest high mineral concentration, and lower ash content shows a low mineral concentration, however, other properties of spices also contribute to their medicinal and nutritional value [8].

Fig 1: Percent moisture content, solubility and ash content of turmeric, clove, cumin, cinnamon, garlic, black pepper, mustard and fenugreek.
The preliminary phytochemical screening of turmeric (Curcuma longa), black pepper (Piper nigrum), fenugreek (Trigonella foenum-graecum), garlic (Allium sativum), mustard (Brassica repa), clove (Syzygium aromaticum), cumin (Cuminum cyminum) and cinnamon (Cinnamomum verum) revealed the presence of different kinds of bioactive secondary metabolites that included alkaloids, tannins, terpenoids, flavonoids, carbohydrates and proteins test spices which confirm the earlier findings of Oladeji et al. [5]. The qualitative analysis of spices for the presence of different phytochemical of spices in aqueous extract is shown in Table 2 and the tests in Fig. 2. We used water extracts for phytochemical analysis in view of the solubility aspects of available biomolecules during metabolism of food products when the spices are incorporated with foods for various purposes. The previous authors have used various organic solvents for extraction of biomolecules from spices and the antimicrobial activities were determined by them using DMSO as solvent after extraction and evaporation in different organic solvents. Such method and approach of the previous investigators is not close to natural conditions, hence, we conducted all experiments with water extracts of the spices as these will be available to the human during their consumption with various food products.
Table 2: Phytochemical screening of aqueous extract of selected Indian spices. (‘+’indicates the presence of phytochemicals and ‘–’ as the absence.
| Phytochemicals | Alkaloids | Flavonoids | Tannin | Terpinoid | Carbohydrate | Protein |
| Spices | ||||||
| Turmeric | + | + | + | + | + | + |
| Garlic | + | + | - | + | + | + |
| Fenugreek | + | + | - | + | + | + |
| Black pepper | + | + | - | + | + | + |
| Cumin | + | + | + | + | + | + |
| Cinnamon | + | + | + | + | + | + |
| Clove | + | + | + | + | + | + |
| Mustard | + | + | - | + | + | + |
Alkaloids are significant bioactive molecules that have antibacterial, antiviral, and insecticidal properties as well as they show antimicrobial activity against a variety of food-borne illnesses causing bacteria [46]. Flavonoids are necessary class of natural products and their abundance in these spices have many medicinal properties. Flavonoids are important for plants as they remove harmful light, as photoreceptors, optical attractants, bug deterrents, antibiotics, antioxidants, disinfectants, and antimicrobial. Flavonoids possess antiviral, anti-inflammatory, and vasodilators properties. Flavonoids demonstrate antioxidant activity because they can both eliminate the production of free radicals and scavenge existing ones. However, flavonoids' antioxidant activity is a result of their capacity to both prevent the production of free radicals and scavenge existing ones [47]. Terpenoids have numerous biological properties, including tumor chemopreventive, antibacterial, antifungal, antiviral, anti-hyperglycemic, anti-inflammatory, anti-parasitic action, and memory boosters [32 a, b]. Terpene can also be used to increase skin penetration and protect against autoimmune disorders. Terpenes can also be converted into adhesives, glues, pesticides, curing agents, and other compounds utilized in agriculture, chemistry, and other fields [48]. Tanninsare widely used in alcoholic beverages as a clarifying agents and as a flavoring component in both alcoholic as well as nonalcoholic beverages and juices. Tannins originated from a variety of plant-based sources and are also frequently utilized in the wine industry. Tannins can also be used as a mordant, which is especially useful in the natural dyeing of cellulose fibers like cotton [27]

(A) (B) (C)

(D) (E) (F)
Figure 2: Qualitative analysis of phytochemicals of spices (A) Alkaloid, (B). Flavonoids, (C) Terpenoids, (D) Tannins, (E) Carbohydrates (F) Proteins.
Carbohydrates metabolism is an important process that provides a constant supply of energy for living cells. The body produces glucose from carbohydrates, which is then turned into energy to power biological functions and physical activities. Carbohydrates are abundant and have several biological roles [10]. Carbohydrate-based or carbohydrate-modified medications are frequently employed in cardiovascular and haematological treatments spanning from inflammatory disorders and antithrombotic therapy to wound healing [30]. They give energy, help in the regulation of blood sugar and insulin metabolism, aid in the metabolism of cholesterol and triglycerides, and promote fermentation [32 a, b]. When sugar is ingested, the digestive tract begins the process of breaking it down into glucose, which is required for energy. Proteins help to repair and development of bodily tissues and boosts immunity while stimulating metabolic activities, balancing pH and fluid balance. Protein also helps in boost our immune system [49].
All experimentsto measure the zone of antibacterial activity (inhibition) were conducted in triplets, and the zone of activity was determined in mm in diameter by considering both the X and Y axes, from which the disc diameter (X2) was subtracted and then divided by 4 to calculate the average zone of inhibition. On comparison of data presented in Table 3 with simple standard error, reveals that aqueous extract of black pepper was highly active against Staphylococcus aureus (ATCC6539), Bacillus subtilis (ATCC6633), Salmonella enterica (ATCC14028) and Escherichia coli (ATCC8739) while water extract of clove showed high activity only against Shigella flexneri (ATCC12022) and S. enterica. It may be because of presence of large amounts water insoluble clove oil not extracted in aqueous extract. Gupta et al. [6a, b, & 50] had earlier showed high activity of cinnamon, herbal and clove oils with organic solvents and tested their anti-microbial activities with Dimethyl sulfoxide (DMSO) as solvent. The biomolecules soluble in organic solvents are not normally available to the organisms in active form under natural conditions, and the present study with aqueous extract of spices against food borne and Enteropathogens is more relevant as far as their availability in natural conditions is concerned. Salmonella enterica (ATCC14028) and Escherichia coli (ATCC8739) were inhibited by aqueous extract of all test spices - turmeric, black pepper, fenugreek, garlic, mustard, clove, cumin and cinnamon (Table 3). Bacillus subtillis (ATCC6633) was inhibited by turmeric, black pepper and garlic while Staphylococcus aureus (ATCC6539 was highly sensitive to black pepper and turmeric. Prakash et al. (2023) [51] in our laboratories have isolated a large number of mupirocin resistant Staphylococcus aureus strains and we found that some of these resistant strains were sensitive to aqueous extracts of black pepper and we are conducting further experiments to find out the active biomolecules that can inhibit the growth of antibiotic resistant Staphylococci. Cronobacter sakazakii (ATCC28544) was selectively sensitive to fenugreek, cumin and cinnamon while Shigella flexneri (ATCC12022) was sensitive to clove, mustard and cinnamon and Pseudomonas aeruginosa (ATCC9027) showed sensitive to aqueous extracts of cinnamon alone. Vibrio cholerae (ATCC 3906) showed resistant against all aqueous extracts of the test spices. This selective anti-bacterial activities of the spices may be attributed to varying amounts of phytochemicals in aqueous extracts of the test spices (Table 3, Fig 3).
For thousands of years, spices have been used in food preservation, medicines, supplements, additives in foods for flavour taste and colour, including as herbal remedies [52]. Scientific research on traditionally used medicinal herbs in their natural available state as aqueous extracts is critical for improving medical standards [40]. Spices and their byproducts are perfect substitutes in food preservation methods, maintaining the consistency of biological and nutritional qualities, as well as the quality and safety of the food products [53]. The plant's therapeutic qualities may be due to the presence of various phytochemicals that exhibit antioxidant and antibacterial effects [40]. Phytochemical screening suggested the presence of phytochemicals such as alkaloids, saponins, flavonoids, phenols, tannins, glycosides, and carbohydrates in aqueous extracts of the spices tested in the present study which confirms the earlier reports of Abdisa and Kenea [54]. Antimicrobial activity of black pepper is very popular [4] and has great pharmaceutical value in the prevention and cure of cough and cold including the oral congestion [31a, b] have found Staphylococcus aureus as the most common causal organism of bacterial infection in the mouth and the high antibacterial activity of black pepper in the present study against Staphylococcus aureus confirm its medicinal property. Black pepper has considerable antibacterial activity and is used in traditional medicine to treat a variety of diseases [55]. Turmeric has been used to treat coughs, bronchitis, chest asthma, and colds for centuries, and its therapeutic effectiveness has been related to the existence of natural metabolites present in its root (rhizome), notably curcumin and cinole, which have anticancer and anti-inflammatory activities [56]. Scientific literature shows that garlic possess considerable levels of different important elements like vitamin C and vitamin B6, which are required for human health [23] besides several antimicrobial components. Fenugreek (Trigonella foenum-graecum) contains trigonelline, choline, gentianine, and carpaine, that show high biological activity in the neurological, cardiovascular, and anti-diabetic systems [57], was active Salmonella enterica, E. coli and Cronobacter sakazakii. Use of spice consumption has been linked to a variety of health benefits [30] including significant antimicrobial actions [58]. These properties are mostly due to the presence of biologically active chemicals that inhibit the growth of pathogenic and food-spoilage organisms [59]. Yeasts like Candida albicans, Aspergillus spp. and Penicillium spp. [60] and bacteria like E. coli and Staphylococcus aureus, well-known opportunistic microbes (normal components of human microbiota) can cause diseases in gastrointestinal tract, skin, soft tissue, circulatory system, respiratory system, and urogenital system [61]. Screening and identification of natural herbal parts as antimicrobial agents can reduce the need for antibiotics to treat specific conditions and also by preventing the formation of antibiotic resistance [62] Around 80 % of the world population continue to rely on plants for their healthcare, and 95% of modern medications have been derived from traditional medicinal plants [63]. This study is unique from the point of view that throughout the investigation we have used aqueous extract of spices for phytochemical screening as well as for antibacterial testing to find out their actual role as additives in food products.
Table 3. Zone (mm) of antibacterial (inhibition) of aqueous extract of spices against test bacteria on Müller-Hinton agar medium. Each figure is an average of three independent replicates
| Spices | Turmeric | Black pepper | Fenugreek | Garlic | Mustard | Clove | Cumin | Cinnamon |
| Pathogens | ||||||||
| Bacillus subtilis (ATCC 6633) | 15±1.1 | 20.5±1.1 | 11±1.0 | 14.25±1.2 | 10.6±1.4 | 6.4±1.1 | 6.4±1.0 | 6.7±1.5 |
| Salmonella enterica (ATCC 14028) | 14±1.0 | 16±1.0 | 15±1.0 | 15±1.3 | 13±1 | 15±1.2 | 13.3±1.2 | 9.2±1.0 |
| Staphylococcus aureus (ATCC 6539) | 15±1.2 | 21.5±1.3 | 8.5±1.1 | 11.5±1.0 | 7±1.0 | 3.1±1.1 | 5.4±1.1 | 5±1.0 |
| Escherichia coli (ATCC 8739) | 11±1.0 | 15.25±1.2 | 12.75±1.2 | 14.75±1.1 | 12.4±1.5 | 13.4±1.0 | 14.5±1.0 | 6±1.1 |
| Cronobacter sakazakii (ATCC 29544) | 6±1.0 | 11.2±1.2 | 12.1±1.1 | 9±1.3 | 9±1.0 | 6±1.2 | 14±1.2 | 16±1.0 |
| Shigella flexneri (ATCC 12022) | 6±1.3 | 7±1.2 | 11±1.0 | 9.5±1.2 | 12.1±1.1 | 16±1.0 | 13±1.0 | 12±1.2 |
| Pseudomonas aeruginosa (ATCC 9027) | 9±1.2 | 8±1.0 | 10.5±1.2 | 11±1.0 | 9.3±1.2 | 11±1.2 | 9.1±1.1 | 12.5±1.2 |
| Vibrio cholerae (ATCC 3906) | 10±1.0 | 7.1±1.1 | 5.5±1.2 | 7.4±1.1 | 8.3±1.2 | 7±1.0 | 8±1.0 | 7.5±1.2 |
(A) (B)

(C) (D
(E) (F)

(G) (H)
Fig 3: Antimicrobial Activity of spices against common food borne pathogens zone of Inhibition (A) Bacillus subtilis (ATCC 6633), (B) Staphylococcus aureus (ATCC 6538), (C) Escherichia coli (ATCC 8739),(D) Cronobacter sakazakii (ATCC 29544) (E) Vibrio cholerae (ATCC 3906) (F) Shigella flexneri (ATCC 12022) (G) Pseudomonas aeruginosa (ATCC 9027) and (H) Salmonella enterica (ATCC 14028).
Black pepper exhibited highest activity against Staphylococcus aureus, Bacillus subtilis, Salmonella enterica, and Escherichia coli as compared to turmeric, garlic, cumin, clove, cinnamon, mustard and fenugreek whereas cinnamon showed highest zone of antibacterial (inhibition) against Cronobacter sakazakii and Pseudomonas aeruginosa. Aqueous extracts of clove exhibited antibacterial activity against Shigella flexneri, Salmonella enterica and E. coli. Cumin was moderately active against E. coli, Cronobacter sakazakii, Salmonella enterica and Shigella flexneri. Similarly, garlic was active against Salmonella flexneri, E. coli and Bacillus subtilis. Turmeric showed highest zone of antibacterial activity against Bacillus subtilis, Salmonella enterica and Staphylococcus aureus while Vibrio cholerae showed moderate sensitivity to test spices turmeric, clove, garlic, cumin, cinnamon, black pepper, mustard and fenugreek. It may safely be concluded that all spices have antibacterial activities against one or the other food borne and Enteropathogens and none of the spice is active against all test pathogens. It, is therefore, suggested that a combination of spices in Indian kitchen as additive in food products is advantageous over single use of an spice. The constituent phytochemicals of Indian spices have pharmaceutical and medicinal properties and their active water soluble components need to be further purified, identified and documented as part of Ayurveda.
The authors declare that they have no conflict of interest
Clearly Auctoresonline and particularly Psychology and Mental Health Care Journal is dedicated to improving health care services for individuals and populations. The editorial boards' ability to efficiently recognize and share the global importance of health literacy with a variety of stakeholders. Auctoresonline publishing platform can be used to facilitate of optimal client-based services and should be added to health care professionals' repertoire of evidence-based health care resources.

Journal of Clinical Cardiology and Cardiovascular Intervention The submission and review process was adequate. However I think that the publication total value should have been enlightened in early fases. Thank you for all.

Journal of Women Health Care and Issues By the present mail, I want to say thank to you and tour colleagues for facilitating my published article. Specially thank you for the peer review process, support from the editorial office. I appreciate positively the quality of your journal.
Journal of Clinical Research and Reports I would be very delighted to submit my testimonial regarding the reviewer board and the editorial office. The reviewer board were accurate and helpful regarding any modifications for my manuscript. And the editorial office were very helpful and supportive in contacting and monitoring with any update and offering help. It was my pleasure to contribute with your promising Journal and I am looking forward for more collaboration.

We would like to thank the Journal of Thoracic Disease and Cardiothoracic Surgery because of the services they provided us for our articles. The peer-review process was done in a very excellent time manner, and the opinions of the reviewers helped us to improve our manuscript further. The editorial office had an outstanding correspondence with us and guided us in many ways. During a hard time of the pandemic that is affecting every one of us tremendously, the editorial office helped us make everything easier for publishing scientific work. Hope for a more scientific relationship with your Journal.

The peer-review process which consisted high quality queries on the paper. I did answer six reviewers’ questions and comments before the paper was accepted. The support from the editorial office is excellent.

Journal of Neuroscience and Neurological Surgery. I had the experience of publishing a research article recently. The whole process was simple from submission to publication. The reviewers made specific and valuable recommendations and corrections that improved the quality of my publication. I strongly recommend this Journal.

Dr. Katarzyna Byczkowska My testimonial covering: "The peer review process is quick and effective. The support from the editorial office is very professional and friendly. Quality of the Clinical Cardiology and Cardiovascular Interventions is scientific and publishes ground-breaking research on cardiology that is useful for other professionals in the field.

Thank you most sincerely, with regard to the support you have given in relation to the reviewing process and the processing of my article entitled "Large Cell Neuroendocrine Carcinoma of The Prostate Gland: A Review and Update" for publication in your esteemed Journal, Journal of Cancer Research and Cellular Therapeutics". The editorial team has been very supportive.

Testimony of Journal of Clinical Otorhinolaryngology: work with your Reviews has been a educational and constructive experience. The editorial office were very helpful and supportive. It was a pleasure to contribute to your Journal.

Dr. Bernard Terkimbi Utoo, I am happy to publish my scientific work in Journal of Women Health Care and Issues (JWHCI). The manuscript submission was seamless and peer review process was top notch. I was amazed that 4 reviewers worked on the manuscript which made it a highly technical, standard and excellent quality paper. I appreciate the format and consideration for the APC as well as the speed of publication. It is my pleasure to continue with this scientific relationship with the esteem JWHCI.

This is an acknowledgment for peer reviewers, editorial board of Journal of Clinical Research and Reports. They show a lot of consideration for us as publishers for our research article “Evaluation of the different factors associated with side effects of COVID-19 vaccination on medical students, Mutah university, Al-Karak, Jordan”, in a very professional and easy way. This journal is one of outstanding medical journal.
Dear Hao Jiang, to Journal of Nutrition and Food Processing We greatly appreciate the efficient, professional and rapid processing of our paper by your team. If there is anything else we should do, please do not hesitate to let us know. On behalf of my co-authors, we would like to express our great appreciation to editor and reviewers.

As an author who has recently published in the journal "Brain and Neurological Disorders". I am delighted to provide a testimonial on the peer review process, editorial office support, and the overall quality of the journal. The peer review process at Brain and Neurological Disorders is rigorous and meticulous, ensuring that only high-quality, evidence-based research is published. The reviewers are experts in their fields, and their comments and suggestions were constructive and helped improve the quality of my manuscript. The review process was timely and efficient, with clear communication from the editorial office at each stage. The support from the editorial office was exceptional throughout the entire process. The editorial staff was responsive, professional, and always willing to help. They provided valuable guidance on formatting, structure, and ethical considerations, making the submission process seamless. Moreover, they kept me informed about the status of my manuscript and provided timely updates, which made the process less stressful. The journal Brain and Neurological Disorders is of the highest quality, with a strong focus on publishing cutting-edge research in the field of neurology. The articles published in this journal are well-researched, rigorously peer-reviewed, and written by experts in the field. The journal maintains high standards, ensuring that readers are provided with the most up-to-date and reliable information on brain and neurological disorders. In conclusion, I had a wonderful experience publishing in Brain and Neurological Disorders. The peer review process was thorough, the editorial office provided exceptional support, and the journal's quality is second to none. I would highly recommend this journal to any researcher working in the field of neurology and brain disorders.

Dear Agrippa Hilda, Journal of Neuroscience and Neurological Surgery, Editorial Coordinator, I trust this message finds you well. I want to extend my appreciation for considering my article for publication in your esteemed journal. I am pleased to provide a testimonial regarding the peer review process and the support received from your editorial office. The peer review process for my paper was carried out in a highly professional and thorough manner. The feedback and comments provided by the authors were constructive and very useful in improving the quality of the manuscript. This rigorous assessment process undoubtedly contributes to the high standards maintained by your journal.

International Journal of Clinical Case Reports and Reviews. I strongly recommend to consider submitting your work to this high-quality journal. The support and availability of the Editorial staff is outstanding and the review process was both efficient and rigorous.

Thank you very much for publishing my Research Article titled “Comparing Treatment Outcome Of Allergic Rhinitis Patients After Using Fluticasone Nasal Spray And Nasal Douching" in the Journal of Clinical Otorhinolaryngology. As Medical Professionals we are immensely benefited from study of various informative Articles and Papers published in this high quality Journal. I look forward to enriching my knowledge by regular study of the Journal and contribute my future work in the field of ENT through the Journal for use by the medical fraternity. The support from the Editorial office was excellent and very prompt. I also welcome the comments received from the readers of my Research Article.

Dear Erica Kelsey, Editorial Coordinator of Cancer Research and Cellular Therapeutics Our team is very satisfied with the processing of our paper by your journal. That was fast, efficient, rigorous, but without unnecessary complications. We appreciated the very short time between the submission of the paper and its publication on line on your site.

I am very glad to say that the peer review process is very successful and fast and support from the Editorial Office. Therefore, I would like to continue our scientific relationship for a long time. And I especially thank you for your kindly attention towards my article. Have a good day!

"We recently published an article entitled “Influence of beta-Cyclodextrins upon the Degradation of Carbofuran Derivatives under Alkaline Conditions" in the Journal of “Pesticides and Biofertilizers” to show that the cyclodextrins protect the carbamates increasing their half-life time in the presence of basic conditions This will be very helpful to understand carbofuran behaviour in the analytical, agro-environmental and food areas. We greatly appreciated the interaction with the editor and the editorial team; we were particularly well accompanied during the course of the revision process, since all various steps towards publication were short and without delay".

I would like to express my gratitude towards you process of article review and submission. I found this to be very fair and expedient. Your follow up has been excellent. I have many publications in national and international journal and your process has been one of the best so far. Keep up the great work.

We are grateful for this opportunity to provide a glowing recommendation to the Journal of Psychiatry and Psychotherapy. We found that the editorial team were very supportive, helpful, kept us abreast of timelines and over all very professional in nature. The peer review process was rigorous, efficient and constructive that really enhanced our article submission. The experience with this journal remains one of our best ever and we look forward to providing future submissions in the near future.

I am very pleased to serve as EBM of the journal, I hope many years of my experience in stem cells can help the journal from one way or another. As we know, stem cells hold great potential for regenerative medicine, which are mostly used to promote the repair response of diseased, dysfunctional or injured tissue using stem cells or their derivatives. I think Stem Cell Research and Therapeutics International is a great platform to publish and share the understanding towards the biology and translational or clinical application of stem cells.

I would like to give my testimony in the support I have got by the peer review process and to support the editorial office where they were of asset to support young author like me to be encouraged to publish their work in your respected journal and globalize and share knowledge across the globe. I really give my great gratitude to your journal and the peer review including the editorial office.

I am delighted to publish our manuscript entitled "A Perspective on Cocaine Induced Stroke - Its Mechanisms and Management" in the Journal of Neuroscience and Neurological Surgery. The peer review process, support from the editorial office, and quality of the journal are excellent. The manuscripts published are of high quality and of excellent scientific value. I recommend this journal very much to colleagues.

Dr.Tania Muñoz, My experience as researcher and author of a review article in The Journal Clinical Cardiology and Interventions has been very enriching and stimulating. The editorial team is excellent, performs its work with absolute responsibility and delivery. They are proactive, dynamic and receptive to all proposals. Supporting at all times the vast universe of authors who choose them as an option for publication. The team of review specialists, members of the editorial board, are brilliant professionals, with remarkable performance in medical research and scientific methodology. Together they form a frontline team that consolidates the JCCI as a magnificent option for the publication and review of high-level medical articles and broad collective interest. I am honored to be able to share my review article and open to receive all your comments.

“The peer review process of JPMHC is quick and effective. Authors are benefited by good and professional reviewers with huge experience in the field of psychology and mental health. The support from the editorial office is very professional. People to contact to are friendly and happy to help and assist any query authors might have. Quality of the Journal is scientific and publishes ground-breaking research on mental health that is useful for other professionals in the field”.

Dear editorial department: On behalf of our team, I hereby certify the reliability and superiority of the International Journal of Clinical Case Reports and Reviews in the peer review process, editorial support, and journal quality. Firstly, the peer review process of the International Journal of Clinical Case Reports and Reviews is rigorous, fair, transparent, fast, and of high quality. The editorial department invites experts from relevant fields as anonymous reviewers to review all submitted manuscripts. These experts have rich academic backgrounds and experience, and can accurately evaluate the academic quality, originality, and suitability of manuscripts. The editorial department is committed to ensuring the rigor of the peer review process, while also making every effort to ensure a fast review cycle to meet the needs of authors and the academic community. Secondly, the editorial team of the International Journal of Clinical Case Reports and Reviews is composed of a group of senior scholars and professionals with rich experience and professional knowledge in related fields. The editorial department is committed to assisting authors in improving their manuscripts, ensuring their academic accuracy, clarity, and completeness. Editors actively collaborate with authors, providing useful suggestions and feedback to promote the improvement and development of the manuscript. We believe that the support of the editorial department is one of the key factors in ensuring the quality of the journal. Finally, the International Journal of Clinical Case Reports and Reviews is renowned for its high- quality articles and strict academic standards. The editorial department is committed to publishing innovative and academically valuable research results to promote the development and progress of related fields. The International Journal of Clinical Case Reports and Reviews is reasonably priced and ensures excellent service and quality ratio, allowing authors to obtain high-level academic publishing opportunities in an affordable manner. I hereby solemnly declare that the International Journal of Clinical Case Reports and Reviews has a high level of credibility and superiority in terms of peer review process, editorial support, reasonable fees, and journal quality. Sincerely, Rui Tao.

Clinical Cardiology and Cardiovascular Interventions I testity the covering of the peer review process, support from the editorial office, and quality of the journal.

Clinical Cardiology and Cardiovascular Interventions, we deeply appreciate the interest shown in our work and its publication. It has been a true pleasure to collaborate with you. The peer review process, as well as the support provided by the editorial office, have been exceptional, and the quality of the journal is very high, which was a determining factor in our decision to publish with you.
The peer reviewers process is quick and effective, the supports from editorial office is excellent, the quality of journal is high. I would like to collabroate with Internatioanl journal of Clinical Case Reports and Reviews journal clinically in the future time.

Clinical Cardiology and Cardiovascular Interventions, I would like to express my sincerest gratitude for the trust placed in our team for the publication in your journal. It has been a true pleasure to collaborate with you on this project. I am pleased to inform you that both the peer review process and the attention from the editorial coordination have been excellent. Your team has worked with dedication and professionalism to ensure that your publication meets the highest standards of quality. We are confident that this collaboration will result in mutual success, and we are eager to see the fruits of this shared effort.

Dear Dr. Jessica Magne, Editorial Coordinator 0f Clinical Cardiology and Cardiovascular Interventions, I hope this message finds you well. I want to express my utmost gratitude for your excellent work and for the dedication and speed in the publication process of my article titled "Navigating Innovation: Qualitative Insights on Using Technology for Health Education in Acute Coronary Syndrome Patients." I am very satisfied with the peer review process, the support from the editorial office, and the quality of the journal. I hope we can maintain our scientific relationship in the long term.
Dear Monica Gissare, - Editorial Coordinator of Nutrition and Food Processing. ¨My testimony with you is truly professional, with a positive response regarding the follow-up of the article and its review, you took into account my qualities and the importance of the topic¨.

Dear Dr. Jessica Magne, Editorial Coordinator 0f Clinical Cardiology and Cardiovascular Interventions, The review process for the article “The Handling of Anti-aggregants and Anticoagulants in the Oncologic Heart Patient Submitted to Surgery” was extremely rigorous and detailed. From the initial submission to the final acceptance, the editorial team at the “Journal of Clinical Cardiology and Cardiovascular Interventions” demonstrated a high level of professionalism and dedication. The reviewers provided constructive and detailed feedback, which was essential for improving the quality of our work. Communication was always clear and efficient, ensuring that all our questions were promptly addressed. The quality of the “Journal of Clinical Cardiology and Cardiovascular Interventions” is undeniable. It is a peer-reviewed, open-access publication dedicated exclusively to disseminating high-quality research in the field of clinical cardiology and cardiovascular interventions. The journal's impact factor is currently under evaluation, and it is indexed in reputable databases, which further reinforces its credibility and relevance in the scientific field. I highly recommend this journal to researchers looking for a reputable platform to publish their studies.

Dear Editorial Coordinator of the Journal of Nutrition and Food Processing! "I would like to thank the Journal of Nutrition and Food Processing for including and publishing my article. The peer review process was very quick, movement and precise. The Editorial Board has done an extremely conscientious job with much help, valuable comments and advices. I find the journal very valuable from a professional point of view, thank you very much for allowing me to be part of it and I would like to participate in the future!”

Dealing with The Journal of Neurology and Neurological Surgery was very smooth and comprehensive. The office staff took time to address my needs and the response from editors and the office was prompt and fair. I certainly hope to publish with this journal again.Their professionalism is apparent and more than satisfactory. Susan Weiner

My Testimonial Covering as fellowing: Lin-Show Chin. The peer reviewers process is quick and effective, the supports from editorial office is excellent, the quality of journal is high. I would like to collabroate with Internatioanl journal of Clinical Case Reports and Reviews.

My experience publishing in Psychology and Mental Health Care was exceptional. The peer review process was rigorous and constructive, with reviewers providing valuable insights that helped enhance the quality of our work. The editorial team was highly supportive and responsive, making the submission process smooth and efficient. The journal's commitment to high standards and academic rigor makes it a respected platform for quality research. I am grateful for the opportunity to publish in such a reputable journal.
My experience publishing in International Journal of Clinical Case Reports and Reviews was exceptional. I Come forth to Provide a Testimonial Covering the Peer Review Process and the editorial office for the Professional and Impartial Evaluation of the Manuscript.

I would like to offer my testimony in the support. I have received through the peer review process and support the editorial office where they are to support young authors like me, encourage them to publish their work in your esteemed journals, and globalize and share knowledge globally. I really appreciate your journal, peer review, and editorial office.
Dear Agrippa Hilda- Editorial Coordinator of Journal of Neuroscience and Neurological Surgery, "The peer review process was very quick and of high quality, which can also be seen in the articles in the journal. The collaboration with the editorial office was very good."

I would like to express my sincere gratitude for the support and efficiency provided by the editorial office throughout the publication process of my article, “Delayed Vulvar Metastases from Rectal Carcinoma: A Case Report.” I greatly appreciate the assistance and guidance I received from your team, which made the entire process smooth and efficient. The peer review process was thorough and constructive, contributing to the overall quality of the final article. I am very grateful for the high level of professionalism and commitment shown by the editorial staff, and I look forward to maintaining a long-term collaboration with the International Journal of Clinical Case Reports and Reviews.
To Dear Erin Aust, I would like to express my heartfelt appreciation for the opportunity to have my work published in this esteemed journal. The entire publication process was smooth and well-organized, and I am extremely satisfied with the final result. The Editorial Team demonstrated the utmost professionalism, providing prompt and insightful feedback throughout the review process. Their clear communication and constructive suggestions were invaluable in enhancing my manuscript, and their meticulous attention to detail and dedication to quality are truly commendable. Additionally, the support from the Editorial Office was exceptional. From the initial submission to the final publication, I was guided through every step of the process with great care and professionalism. The team's responsiveness and assistance made the entire experience both easy and stress-free. I am also deeply impressed by the quality and reputation of the journal. It is an honor to have my research featured in such a respected publication, and I am confident that it will make a meaningful contribution to the field.

"I am grateful for the opportunity of contributing to [International Journal of Clinical Case Reports and Reviews] and for the rigorous review process that enhances the quality of research published in your esteemed journal. I sincerely appreciate the time and effort of your team who have dedicatedly helped me in improvising changes and modifying my manuscript. The insightful comments and constructive feedback provided have been invaluable in refining and strengthening my work".

I thank the ‘Journal of Clinical Research and Reports’ for accepting this article for publication. This is a rigorously peer reviewed journal which is on all major global scientific data bases. I note the review process was prompt, thorough and professionally critical. It gave us an insight into a number of important scientific/statistical issues. The review prompted us to review the relevant literature again and look at the limitations of the study. The peer reviewers were open, clear in the instructions and the editorial team was very prompt in their communication. This journal certainly publishes quality research articles. I would recommend the journal for any future publications.

Dear Jessica Magne, with gratitude for the joint work. Fast process of receiving and processing the submitted scientific materials in “Clinical Cardiology and Cardiovascular Interventions”. High level of competence of the editors with clear and correct recommendations and ideas for enriching the article.

We found the peer review process quick and positive in its input. The support from the editorial officer has been very agile, always with the intention of improving the article and taking into account our subsequent corrections.

My article, titled 'No Way Out of the Smartphone Epidemic Without Considering the Insights of Brain Research,' has been republished in the International Journal of Clinical Case Reports and Reviews. The review process was seamless and professional, with the editors being both friendly and supportive. I am deeply grateful for their efforts.
To Dear Erin Aust – Editorial Coordinator of Journal of General Medicine and Clinical Practice! I declare that I am absolutely satisfied with your work carried out with great competence in following the manuscript during the various stages from its receipt, during the revision process to the final acceptance for publication. Thank Prof. Elvira Farina

Dear Jessica, and the super professional team of the ‘Clinical Cardiology and Cardiovascular Interventions’ I am sincerely grateful to the coordinated work of the journal team for the no problem with the submission of my manuscript: “Cardiometabolic Disorders in A Pregnant Woman with Severe Preeclampsia on the Background of Morbid Obesity (Case Report).” The review process by 5 experts was fast, and the comments were professional, which made it more specific and academic, and the process of publication and presentation of the article was excellent. I recommend that my colleagues publish articles in this journal, and I am interested in further scientific cooperation. Sincerely and best wishes, Dr. Oleg Golyanovskiy.

Dear Ashley Rosa, Editorial Coordinator of the journal - Psychology and Mental Health Care. " The process of obtaining publication of my article in the Psychology and Mental Health Journal was positive in all areas. The peer review process resulted in a number of valuable comments, the editorial process was collaborative and timely, and the quality of this journal has been quickly noticed, resulting in alternative journals contacting me to publish with them." Warm regards, Susan Anne Smith, PhD. Australian Breastfeeding Association.

Dear Jessica Magne, Editorial Coordinator, Clinical Cardiology and Cardiovascular Interventions, Auctores Publishing LLC. I appreciate the journal (JCCI) editorial office support, the entire team leads were always ready to help, not only on technical front but also on thorough process. Also, I should thank dear reviewers’ attention to detail and creative approach to teach me and bring new insights by their comments. Surely, more discussions and introduction of other hemodynamic devices would provide better prevention and management of shock states. Your efforts and dedication in presenting educational materials in this journal are commendable. Best wishes from, Farahnaz Fallahian.
Dear Maria Emerson, Editorial Coordinator, International Journal of Clinical Case Reports and Reviews, Auctores Publishing LLC. I am delighted to have published our manuscript, "Acute Colonic Pseudo-Obstruction (ACPO): A rare but serious complication following caesarean section." I want to thank the editorial team, especially Maria Emerson, for their prompt review of the manuscript, quick responses to queries, and overall support. Yours sincerely Dr. Victor Olagundoye.

Dear Ashley Rosa, Editorial Coordinator, International Journal of Clinical Case Reports and Reviews. Many thanks for publishing this manuscript after I lost confidence the editors were most helpful, more than other journals Best wishes from, Susan Anne Smith, PhD. Australian Breastfeeding Association.

Dear Agrippa Hilda, Editorial Coordinator, Journal of Neuroscience and Neurological Surgery. The entire process including article submission, review, revision, and publication was extremely easy. The journal editor was prompt and helpful, and the reviewers contributed to the quality of the paper. Thank you so much! Eric Nussbaum, MD
Dr Hala Al Shaikh This is to acknowledge that the peer review process for the article ’ A Novel Gnrh1 Gene Mutation in Four Omani Male Siblings, Presentation and Management ’ sent to the International Journal of Clinical Case Reports and Reviews was quick and smooth. The editorial office was prompt with easy communication.

Dear Erin Aust, Editorial Coordinator, Journal of General Medicine and Clinical Practice. We are pleased to share our experience with the “Journal of General Medicine and Clinical Practice”, following the successful publication of our article. The peer review process was thorough and constructive, helping to improve the clarity and quality of the manuscript. We are especially thankful to Ms. Erin Aust, the Editorial Coordinator, for her prompt communication and continuous support throughout the process. Her professionalism ensured a smooth and efficient publication experience. The journal upholds high editorial standards, and we highly recommend it to fellow researchers seeking a credible platform for their work. Best wishes By, Dr. Rakhi Mishra.

Dear Jessica Magne, Editorial Coordinator, Clinical Cardiology and Cardiovascular Interventions, Auctores Publishing LLC. The peer review process of the journal of Clinical Cardiology and Cardiovascular Interventions was excellent and fast, as was the support of the editorial office and the quality of the journal. Kind regards Walter F. Riesen Prof. Dr. Dr. h.c. Walter F. Riesen.

Dear Ashley Rosa, Editorial Coordinator, International Journal of Clinical Case Reports and Reviews, Auctores Publishing LLC. Thank you for publishing our article, Exploring Clozapine's Efficacy in Managing Aggression: A Multiple Single-Case Study in Forensic Psychiatry in the international journal of clinical case reports and reviews. We found the peer review process very professional and efficient. The comments were constructive, and the whole process was efficient. On behalf of the co-authors, I would like to thank you for publishing this article. With regards, Dr. Jelle R. Lettinga.

Dear Clarissa Eric, Editorial Coordinator, Journal of Clinical Case Reports and Studies, I would like to express my deep admiration for the exceptional professionalism demonstrated by your journal. I am thoroughly impressed by the speed of the editorial process, the substantive and insightful reviews, and the meticulous preparation of the manuscript for publication. Additionally, I greatly appreciate the courteous and immediate responses from your editorial office to all my inquiries. Best Regards, Dariusz Ziora

Dear Chrystine Mejia, Editorial Coordinator, Journal of Neurodegeneration and Neurorehabilitation, Auctores Publishing LLC, We would like to thank the editorial team for the smooth and high-quality communication leading up to the publication of our article in the Journal of Neurodegeneration and Neurorehabilitation. The reviewers have extensive knowledge in the field, and their relevant questions helped to add value to our publication. Kind regards, Dr. Ravi Shrivastava.

Dear Clarissa Eric, Editorial Coordinator, Journal of Clinical Case Reports and Studies, Auctores Publishing LLC, USA Office: +1-(302)-520-2644. I would like to express my sincere appreciation for the efficient and professional handling of my case report by the ‘Journal of Clinical Case Reports and Studies’. The peer review process was not only fast but also highly constructive—the reviewers’ comments were clear, relevant, and greatly helped me improve the quality and clarity of my manuscript. I also received excellent support from the editorial office throughout the process. Communication was smooth and timely, and I felt well guided at every stage, from submission to publication. The overall quality and rigor of the journal are truly commendable. I am pleased to have published my work with Journal of Clinical Case Reports and Studies, and I look forward to future opportunities for collaboration. Sincerely, Aline Tollet, UCLouvain.

Dear Ms. Mayra Duenas, Editorial Coordinator, International Journal of Clinical Case Reports and Reviews. “The International Journal of Clinical Case Reports and Reviews represented the “ideal house” to share with the research community a first experience with the use of the Simeox device for speech rehabilitation. High scientific reputation and attractive website communication were first determinants for the selection of this Journal, and the following submission process exceeded expectations: fast but highly professional peer review, great support by the editorial office, elegant graphic layout. Exactly what a dynamic research team - also composed by allied professionals - needs!" From, Chiara Beccaluva, PT - Italy.

Dear Maria Emerson, Editorial Coordinator, we have deeply appreciated the professionalism demonstrated by the International Journal of Clinical Case Reports and Reviews. The reviewers have extensive knowledge of our field and have been very efficient and fast in supporting the process. I am really looking forward to further collaboration. Thanks. Best regards, Dr. Claudio Ligresti
Dear Chrystine Mejia, Editorial Coordinator, Journal of Neurodegeneration and Neurorehabilitation. “The peer review process was efficient and constructive, and the editorial office provided excellent communication and support throughout. The journal ensures scientific rigor and high editorial standards, while also offering a smooth and timely publication process. We sincerely appreciate the work of the editorial team in facilitating the dissemination of innovative approaches such as the Bonori Method.” Best regards, Dr. Matteo Bonori.

I recommend without hesitation submitting relevant papers on medical decision making to the International Journal of Clinical Case Reports and Reviews. I am very grateful to the editorial staff. Maria Emerson was a pleasure to communicate with. The time from submission to publication was an extremely short 3 weeks. The editorial staff submitted the paper to three reviewers. Two of the reviewers commented positively on the value of publishing the paper. The editorial staff quickly recognized the third reviewer’s comments as an unjust attempt to reject the paper. I revised the paper as recommended by the first two reviewers.

Dear Maria Emerson, Editorial Coordinator, Journal of Clinical Research and Reports. Thank you for publishing our case report: "Clinical Case of Effective Fetal Stem Cells Treatment in a Patient with Autism Spectrum Disorder" within the "Journal of Clinical Research and Reports" being submitted by the team of EmCell doctors from Kyiv, Ukraine. We much appreciate a professional and transparent peer-review process from Auctores. All research Doctors are so grateful to your Editorial Office and Auctores Publishing support! I amiably wish our article publication maintained a top quality of your International Scientific Journal. My best wishes for a prosperity of the Journal of Clinical Research and Reports. Hope our scientific relationship and cooperation will remain long lasting. Thank you very much indeed. Kind regards, Dr. Andriy Sinelnyk Cell Therapy Center EmCell

Dear Editorial Team, Clinical Cardiology and Cardiovascular Interventions. It was truly a rewarding experience to work with the journal “Clinical Cardiology and Cardiovascular Interventions”. The peer review process was insightful and encouraging, helping us refine our work to a higher standard. The editorial office offered exceptional support with prompt and thoughtful communication. I highly value the journal’s role in promoting scientific advancement and am honored to be part of it. Best regards, Meng-Jou Lee, MD, Department of Anesthesiology, National Taiwan University Hospital.

Dear Editorial Team, Journal-Clinical Cardiology and Cardiovascular Interventions, “Publishing my article with Clinical Cardiology and Cardiovascular Interventions has been a highly positive experience. The peer-review process was rigorous yet supportive, offering valuable feedback that strengthened my work. The editorial team demonstrated exceptional professionalism, prompt communication, and a genuine commitment to maintaining the highest scientific standards. I am very pleased with the publication quality and proud to be associated with such a reputable journal.” Warm regards, Dr. Mahmoud Kamal Moustafa Ahmed

Dear Maria Emerson, Editorial Coordinator of ‘International Journal of Clinical Case Reports and Reviews’, I appreciate the opportunity to publish my article with your journal. The editorial office provided clear communication during the submission and review process, and I found the overall experience professional and constructive. Best regards, Elena Salvatore.

Dear Mayra Duenas, Editorial Coordinator of ‘International Journal of Clinical Case Reports and Reviews Herewith I confirm an optimal peer review process and a great support of the editorial office of the present journal

Dear Editorial Team, Clinical Cardiology and Cardiovascular Interventions. I am really grateful for the peers review; their feedback gave me the opportunity to reflect on the message and impact of my work and to ameliorate the article. The editors did a great job in addition by encouraging me to continue with the process of publishing.

Dear Cecilia Lilly, Editorial Coordinator, Endocrinology and Disorders, Thank you so much for your quick response regarding reviewing and all process till publishing our manuscript entitled: Prevalence of Pre-Diabetes and its Associated Risk Factors Among Nile College Students, Sudan. Best regards, Dr Mamoun Magzoub.

International Journal of Clinical Case Reports and Reviews is a high quality journal that has a clear and concise submission process. The peer review process was comprehensive and constructive. Support from the editorial office was excellent, since the administrative staff were responsive. The journal provides a fast and timely publication timeline.

Dear Mayra Duenas, Editorial Coordinator of the journal IJCCR, I write here a little on my experience as an author submitting to the International Journal of Clinical Case Reports and Reviews (IJCCR). This was my first submission to IJCCR and my manuscript was inherently an outsider’s effort. It attempted to broadly identify and then make some sense of life’s under-appreciated mysteries. I initially had responded to a request for possible submissions. I then contacted IJCCR with a tentative topic for a manuscript. They quickly got back with an approval for the submission, but with a particular requirement that it be medically relevant. I then put together a manuscript and submitted it. After the usual back-and-forth over forms and formality, the manuscript was sent off for reviews. Within 2 weeks I got back 4 reviews which were both helpful and also surprising. Surprising in that the topic was somewhat foreign to medical literature. My subsequent updates in response to the reviewer comments went smoothly and in short order I had a series of proofs to evaluate. All in all, the whole publication process seemed outstanding. It was both helpful in terms of the paper’s content and also in terms of its efficient and friendly communications. Thank you all very much. Sincerely, Ted Christopher, Rochester, NY.

Dear Grace Pierce, Editorial Coordinator of the journal IJCCR, I had a very positive experience with Auctores - Journal throughout the publication process. The Editorial Team was highly responsive, professional, and supportive at every stage. I would like to extend my sincere thanks to the Editor: Grace Pierce, for her guidance and assistance. The peer-review process was smooth and constructive, helping improve the quality of my work. I would gladly recommend Auctores Journal to fellow researchers and authors. Dr. SABITA SINHA, Medical Oncologist, MD (Electro Homeopathy).

Dear Maria Emerson, Editorial Coordinator of - Journal of Clinical Research and Reports. ''I am pleased to provide this testimonial following the publication of our recent case report in this journal. The peer review process was rigorous, constructive, thorough, and conducted in a timely manner. The reviewers’ comments were thoughtful, detailed, and highly constructive, contributing substantially to the refinement, clarity, and scientific robustness of our manuscript. The process was conducted with professionalism and academic integrity throughout. The support provided by the editorial office was exemplary. Communication was consistently prompt, clear, and courteous at all stages of the submission and publication process. The editorial team demonstrated a high level of organization and responsiveness, ensuring that all queries were addressed efficiently and that the process remained transparent and well-coordinated. The overall quality of the journal is reflected in its strong editorial standards, commitment to scientific excellence, and dedication to publishing clinically meaningful research. It has been a privilege to publish our work in this journal, and we would welcome the opportunity to contribute further in the future.'' Best wishes from, Dr. Efstratios Trogkanis, Cardiologist.
Dear Reader: We have published several articles in the Auctores Publishing, LLC, journal, Clinical Medical Reviews and Reports in recent years (CMRR). This is an ‘open access’ journal and the following are our observations. From the initial invitation to submit an article, to the final edits of galley proofs, we have found CMRR personnel to be professional, responsive, rapid and thorough. This entire process begins with Catherine Mitchell, Editorial Coordinator. She is simply outstanding, and, I believe, unparalleled in her capacity. I cannot imagine a more responsive and dedicated Editorial Coordinator. As I read the dates and timing of her correspondence with us, it seems that she never sleeps. I hope Auctores Publishing, LLC, appreciates her efforts as much as these authors do. Thank you to Auctores Publishing, LLC, to the Editorial Staff/Board, and to Catherine Mitchell from a grateful author(s).

Dear Maria Emerson, Editorial Coordinator of International Journal of Clinical Case Reports and Reviews, What distinguishes International Journal of Clinical Case Report and Review is not only the scientific rigor of its publications, but the intellectual climate in which research is evaluated. The submission process is refreshingly free of unnecessary formal barriers and bureaucratic rituals that often complicate academic publishing without adding real value. The peer-review system is demanding yet constructive, guided by genuine scientific dialogue rather than hierarchical or authoritarian attitudes. Reviewers act as collaborators in improving the manuscript, not as gatekeepers imposing arbitrary standards. This journal offers a rare balance: high methodological standards combined with a respectful, transparent, and supportive editorial approach. In an era where publishing can feel more burdensome than research itself, this platform restores the original purpose of peer review — to refine ideas, not to obstruct them Prof. Perlat Kapisyzi, FCCP PULMONOLOGIST AND THORACIC IMAGING.